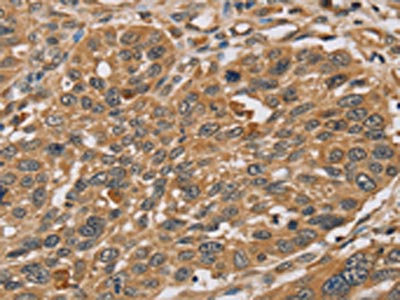

RNF5 Antibody
-
中文名稱:RNF5兔多克隆抗體
-
貨號:CSB-PA034142
-
規格:¥1100
-
圖片:
-
The image on the left is immunohistochemistry of paraffin-embedded Human liver cancer tissue using CSB-PA034142(RNF5 Antibody) at dilution 1/35, on the right is treated with synthetic peptide. (Original magnification: ×200)
-
The image on the left is immunohistochemistry of paraffin-embedded Human lung cancer tissue using CSB-PA034142(RNF5 Antibody) at dilution 1/35, on the right is treated with synthetic peptide. (Original magnification: ×200)
-
Gel: 10%SDS-PAGE, Lysate: 40 μg, Lane 1-5: K562 cells, 231 cells, Jurkat cells, hela cells, 293T cells, Primary antibody: CSB-PA034142(RNF5 Antibody) at dilution 1/200, Secondary antibody: Goat anti rabbit IgG at 1/8000 dilution, Exposure time: 3 minutes
-
-
其他:
產品詳情
-
Uniprot No.:
-
基因名:
-
別名:RNF5; G16; NG2; RMA1; E3 ubiquitin-protein ligase RNF5; Protein G16; RING finger protein 5; RING-type E3 ubiquitin transferase RNF5; Ram1 homolog; HsRma1
-
宿主:Rabbit
-
反應種屬:Human,Mouse,Rat
-
免疫原:Synthetic peptide of Human RNF5
-
免疫原種屬:Homo sapiens (Human)
-
標記方式:Non-conjugated
-
抗體亞型:IgG
-
純化方式:Antigen affinity purification
-
濃度:It differs from different batches. Please contact us to confirm it.
-
保存緩沖液:-20°C, pH7.4 PBS, 0.05% NaN3, 40% Glycerol
-
產品提供形式:Liquid
-
應用范圍:ELISA,WB,IHC
-
推薦稀釋比:
Application Recommended Dilution ELISA 1:2000-1:5000 WB 1:500-1:2000 IHC 1:25-1:100 -
Protocols:
-
儲存條件:Upon receipt, store at -20°C or -80°C. Avoid repeated freeze.
-
貨期:Basically, we can dispatch the products out in 1-3 working days after receiving your orders. Delivery time maybe differs from different purchasing way or location, please kindly consult your local distributors for specific delivery time.
-
用途:For Research Use Only. Not for use in diagnostic or therapeutic procedures.
相關產品
靶點詳情
-
功能:Has E2-dependent E3 ubiquitin-protein ligase activity. May function together with E2 ubiquitin-conjugating enzymes UBE2D1/UBCH5A and UBE2D2/UBC4. Mediates ubiquitination of PXN/paxillin and Salmonella type III secreted protein sopA. May be involved in regulation of cell motility and localization of PXN/paxillin. Mediates the 'Lys-63'-linked polyubiquitination of JKAMP thereby regulating JKAMP function by decreasing its association with components of the proteasome and ERAD; the ubiquitination appears to involve E2 ubiquitin-conjugating enzyme UBE2N. Mediates the 'Lys-48'-linked polyubiquitination of STING1 at 'Lys-150' leading to its proteasomal degradation; the ubiquitination occurs in mitochondria after viral transfection and regulates antiviral responses.
-
基因功能參考文獻:
- we found that RNF5 is differentially expressed in human bronchial epithelia from CF vs. control patients. Our results identify RNF5 as a target for therapeutic modalities to antagonize mutant CFTR proteins. PMID: 26183966
- RNF5 is involved in the regulation of the L-glutamine carrier proteins SLC1A5 and SLC38A2. PMID: 25759021
- Our data suggest that RNF5 regulates the turnover of specific G protein-coupled receptors by ubiquitinating JAMP and preventing proteasome recruitment. PMID: 23798571
- In addition to confirming one of the top findings in the meta-analysis, TRIM26, RNF5 and HLA-DRB3 have been identified as potential candidate genes for schizophrenia. PMID: 22433715
- Rma1, an E3 ubiquitin ligase localized in the ER membrane, is involved in Pendrin degradation PMID: 22750442
- JB12 cooperates with cytosolic Hsc70 and the ubiquitin ligase RMA1 to target CFTR and CFTRDeltaF508 for degradation. PMID: 21148293
- found in cerebral microvessels endothelium PMID: 11603805
- RNF5 regulates cell motility by targeting paxillin ubiquitination and altered localization PMID: 12861019
- the G(16)-mediated activation of IKK/NFkappaB by N(6)-cyclohexyladenosine requires a complex signaling network composed of multiple intermediates PMID: 15485865
- efficient bacterial escape into the cytosol of epithelial cells requires HsRMA1-mediated SopA ubiquitination and contributes to Salmonella-induced enteropathogenicity PMID: 16176924
- RNF5 is a novel regulator of breast cancer progression through its effect on actin cytoskeletal alterations. PMID: 17804730
- RNF5 associates with JAMP in the ER membrane. This association results in Ubc13-dependent RNF5-mediated noncanonical ubiquitination of JAMP. PMID: 19269966
- E3 ubiquitin ligase RNF5 interacted with MITA in a viral-infection-dependent manner PMID: 19285439
顯示更多
收起更多
-
亞細胞定位:Membrane; Multi-pass membrane protein. Mitochondrion membrane. Endoplasmic reticulum membrane. Note=Predominantly located in the plasma membrane, with some localization occurring within cytoplasmic organelles.
-
組織特異性:Widely expressed.
-
數據庫鏈接:
Most popular with customers
-
-
YWHAB Recombinant Monoclonal Antibody
Applications: ELISA, WB, IHC, IF, FC
Species Reactivity: Human, Mouse, Rat
-
Phospho-YAP1 (S127) Recombinant Monoclonal Antibody
Applications: ELISA, WB, IHC
Species Reactivity: Human
-
-
-
-
-